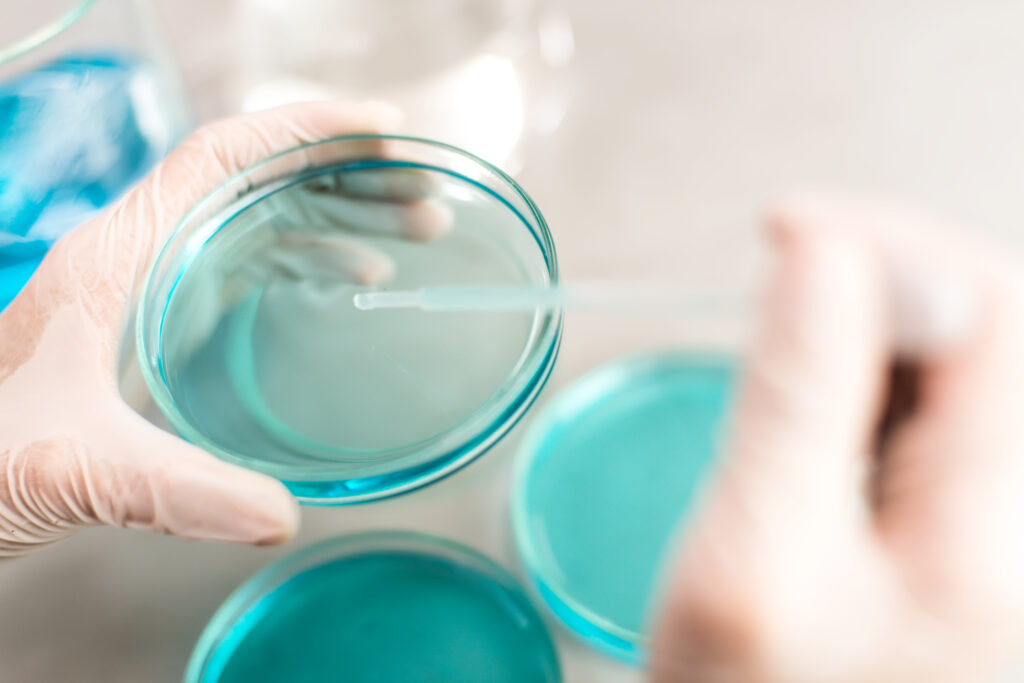
manos-cortadas-realizando-experimentos-con-productos-quimicos-en-el-laboratorio

Fecundación In Vitro (FIV)
Inicio / Reproducción asistida / Fecundación In Vitro
Un Impulso Sencillo a la Fertilidad
La fecundación in vitro es una técnica avanzada de reproducción asistida que consiste en unir los óvulos con los espermatozoides fuera del cuerpo de la mujer, en el laboratorio. De esta unión se obtienen embriones que, tras su desarrollo inicial, se transfieren al útero con el objetivo de lograr el embarazo.
Este procedimiento ofrece tasas de éxito superiores a las de la concepción natural en muchos casos de infertilidad.
Existen dos modalidades principales de FIV:
FIV convencional
Los óvulos se colocan en contacto con los espermatozoides en un medio de cultivo controlado para que la fecundación se produzca de forma espontánea.
ICSI
(Inyección Intracitoplasmática de Espermatozoides)
En esta variante, se selecciona un espermatozoide y se introduce directamente en el óvulo mediante microinyección.
Esta técnica se emplea principalmente cuando el semen presenta una concentración baja, movilidad reducida o alteraciones morfológicas, optimizando así las posibilidades de obtener embriones viables.
Etapas del tratamiento:
1.
Evaluación inicial
Se realiza un estudio completo de la mujer o de la pareja para identificar las causas de infertilidad y diseñar un protocolo personalizado de estimulación ovárica.
2.
Estimulación ovárica
Mediante medicación hormonal controlada, se estimula el ovario para favorecer el desarrollo de varios óvulos maduros. El proceso dura aproximadamente entre 8 y 15 días y se supervisa mediante ecografías.
3.
Punción folicular
(Extracción de óvulos)
En quirófano y bajo sedación, el ginecólogo obtiene los óvulos desarrollados. Es una intervención corta y sin molestias posteriores significativas.
4.
Fecundación en laboratorio
Tras preparar la muestra seminal, se aplica la técnica más adecuada (FIV o ICSI) según las características de cada caso.
5.
Cultivo embrionario
Al día siguiente, se evalúa la fecundación y se mantienen los embriones en medios de cultivo especializados durante varios días, hasta seleccionar los de mejor calidad.
6.
Transferencia embrionaria
Entre el segundo y sexto día tras la fecundación, se introducen los embriones seleccionados en el útero.
Es un procedimiento breve, indoloro y no requiere anestesia. Los embriones sobrantes que cumplan criterios de calidad se vitrifican para futuros intentos.
7.
Prueba de embarazo
Aproximadamente 15 días después de la transferencia, se realiza un test para confirmar si se ha conseguido la gestación.
8.
Ecografía de control
En caso de resultado positivo, se lleva a cabo una ecografía para confirmar el desarrollo del embarazo.
Los tratamientos de reproducción asistida se ofrecen de forma privada en la Clínica Málaga FIV.
Encuéntranos en:
Teléfono
951 000 100
Málaga FIV
Lun - Mie - Vie: 16:00 - 18:00
C. Casapalma, 1,
Distrito Centro,
29008 Málaga
Gutenberg
Miércoles: 10:00 - 13:30
Jueves: 15:45 - 18:45
C/ Gutenberg, 5, Local 16
Málaga-Este,
29016 Málaga
Vithas Limonar
Martes: 10:00 - 13:30
C/ de la Era, 6,
Málaga-Este,
29016 Málaga
Vithas Rincón
Martes: 15.30 - 18:30
Viernes: 10:15 - 13:30
Av. de la Torre, 15
29730 Torre de Benagalbón
Málaga
Vithas Torre del Mar
Jueves: 10:30 - 13:30
C/ San Andres, 23
29740 Torre del Mar
Málaga